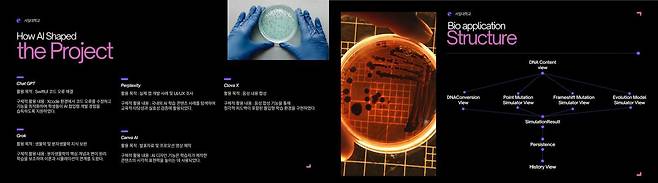
AI 학습 활용 부문 대상작 (서일대학교 AI 활용 분자생물학 교육용 앱 개발)

‘전국 전문대학 AI 활용 콘텐츠 공모전’ 성료 …서일대·안산대 대상
전체 맥락을 이해하기 위해서는 본문 보기를 권장합니다.
전문대학 혁신지원사업 발전협의회에서 주최하고, 교육부와 한국연구재단이 후원한 '전국 전문대학 AI 학습활용 콘텐츠 공모전'이 성황리에 마무리됐다.
전국 혁신지원사업 참여 전문대학에서 200여 팀이 참여한 이번 공모전은 학생들이 학교생활과 전공 학습 속에서 AI를 활용해 제작한 콘텐츠를 겨루는 자리로, 전문대 학생들의 창의성과 실무 역량이 돋보였다는 평가를 받았다.
이 글자크기로 변경됩니다.
(예시) 가장 빠른 뉴스가 있고 다양한 정보, 쌍방향 소통이 숨쉬는 다음뉴스를 만나보세요. 다음뉴스는 국내외 주요이슈와 실시간 속보, 문화생활 및 다양한 분야의 뉴스를 입체적으로 전달하고 있습니다.
AI 기반 창작 역량 확산, 전문대 혁신지원사업 성과 입증

전국 혁신지원사업 참여 전문대학에서 200여 팀이 참여한 이번 공모전은 학생들이 학교생활과 전공 학습 속에서 AI를 활용해 제작한 콘텐츠를 겨루는 자리로, 전문대 학생들의 창의성과 실무 역량이 돋보였다는 평가를 받았다.
이번 공모전은 정부의 ‘AI 기반 고등교육 혁신’ 기조와 맞물려 전문대학 현장에서의 AI 활용 역량을 실질적으로 강화했다는 점에서 정책적 의미도 크다. 교육부가 추진 중인 ‘AI·디지털 인재 양성 정책’과도 부합하며, 전문대학이 지역산업과 현장 중심 교육에서 AI를 적극적으로 도입하는 사례를 넓혀가는 계기가 됐다.
공모전 심사 결과 총 29팀이 수상 명단에 이름을 올렸으며, 서일대학교 소프트웨어공학과 강승우 학생과 안산대학교 융합디자인학부 조휘상·송재혁·구미영·김용하 팀이 대상으로 선정됐다.
우수상에는 청강문화산업대학교, 서울예술대학교, 인하공업전문대학교, 영남이공대학교, 충북보건과학대학교 등 총 8팀이 선정됐다. 장려상은 대전과학기술대, 경인여대, 부산보건대, 충청대, 재능대, 서영대, 동아방송예술대, 경남정보대 등 총 15팀이 수상했으며, 간호·치기공학·패션뷰티·영상제작·AI 학과 등 다양한 전공이 고르게 이름을 올렸다.
심사위원단은 작품의 창의성·실용성·완성도·확산성을 중심으로 평가했으며, “학생들이 AI를 단순히 기술로 소비하는 것이 아니라 학습·창작의 파트너로 활용하는 수준까지 도달한 점이 인상적이었다”고 평가했다. 또 다른 심사위원은 “ChatGPT를 활용한 스크립트 작성, Midjourney를 활용한 이미지 생성, Runway를 활용한 영상 자동편집 등 최신 AI 기술을 자연스럽게 접목해 실무적 활용 가능성을 보여주고 있다. 전공과 관계없이 AI 적용 방식이 다양해지고 있으며 전문대 학생들의 실무 역량이 빠르게 성장하고 있다”고 밝혔다.
전문대학 혁신지원사업 발전협의회 윤우영 회장은 “학생들이 AI를 활용해 전공 영역을 확장하고 새로운 방식으로 문제를 해결하는 모습은 전문대학 교육혁신의 가능성을 보여주는 중요한 신호”라며 “수상작을 모아 우수사례집으로 발간해 전국 전문대에 확산할 계획”이라고 밝혔다.
이번 공모전은 전문대학 혁신지원사업의 목표인 AI 기반 교육혁신·창의융합 인재 양성의 성과를 대외적으로 입증한 사례로 평가받고 있다. 수상작들은 향후 교육자료, 비교과 프로그램, 지역사회 확산 콘텐츠로 적극 활용될 예정이다.
최용석 기자 duck8@donga.com
Copyright © 동아일보. All rights reserved. 무단 전재, 재배포 및 AI학습 이용 금지
- “트럼프는 알코올 중독자 성격”…백악관 비서실장 폭탄 발언
- ‘치매머니 사냥’ 요양원의 비극…701호 동생, 702호 아들에 뜯겨[히어로콘텐츠/헌트③-上]
- 질타하던 李대통령도 웃었다…“엄청 똑똑한 듯. 데려다 쓰자”
- 우크라, 러시아 잠수함 폭파 영상 공개…러 “피해 없어” 부인 (영상)
- 트럼프 “베네수엘라 정권, 외국 테러조직 지정…유조선 완전 봉쇄”
- 교통체증 위를 난다…하늘 나는 자동차 “최고 시속 177㎞”
- “슈퍼우먼처럼 나타났다”…경찰서에 도착한 감사편지
- [박중현 칼럼]李 국정에 의문 생긴다면 ‘질책’ 아닌 ‘자문’해야
- 김종혁 “민주주의 돌로 쳐 죽이려는 자들에 맞서 싸우겠다”
- 김병기, ‘쿠팡대표와 70만원 식사’ 보도에 “난 3만8000원 파스타 주문”